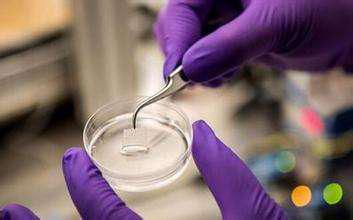
「突破」清华大学徐弢团队首次利用微型机器人+体内生物打印治疗胃创伤

本文为转化医学网原创,转载请注明出处
作者:竹子
导言:胃壁损伤是的常见的消化道问题,全球约有12%的人在不同程度上患有胃壁损伤。生物打印技术,将新细胞直接递送至损伤部位修复组织,这为治疗该问题提供了一种潜在的有用方法。困难在于当前的生物打印技术集中在人体外,而且生物打印机通常很大,不做有创手术就不能为内部组织修复提供足够的空间进行打印操作。为了克服这个问题,清华徐弢等开发了一种微型机器人,该机器人通过内窥镜进入人体,以在体内进行组织修复。

原位体内生物打印示意图,以治疗胃壁损伤为例
徐弢教授等科学家首先提出了原位体内生物打印的概念, 以解决传统生物打印中的现有缺陷。他们表示,通过使用微型机器人结合“原位体内生物打印”的新概念在体内进行了组织修复,已经向治疗胃创伤的新方法迈出了第一步。该研究发表在《生物制造》上。

在这项研究中,研究人员开发了一种可安装到内窥镜上的微型生物打印平台,用于进入人体并进行生物打印。该平台的设计和制造中采用了印刷电路、微机电系统技术。他们还开发了高精度控制系统,并进行了性能测试,以验证该平台的可行性。

生物打印平台的制造
2层组织支架在胃模型打印。以人胃上皮细胞和人胃平滑肌细胞作生物墨水,用来模拟胃的解剖结构。10 d细胞培养表明,打印的细胞仍保持较高的生存能力和稳定的增殖,这表明打印的组织支架中,细胞具有良好的生物学功能。这项工作不仅在生物打印领域,而且在临床科学领域都展现了创新性的进步。

10 d细胞培养过程中细胞形态变化的图像:显示细胞在第0天呈球形,并随着细胞的扩散和增殖逐渐变成纺锤状或菱形。
徐教授和他的博士生赵文祥开发的生物打印平台是由固定基座、移动平台和三个相同的运动链组成的Delta机器人。为了尽可能地降低侵入性,它可以在进入患者体内时折叠起来,然后在开始生物打印操作之前展开。
他们用两种方式对系统进行了测试。首先,通过人胃和内窥镜的生物学模型,模拟该过程的插入和打印操作元素。其次,他们在细胞培养皿中进行了生物打印试验,以测试该设备在生物打印活细胞和修复创面的有效性。
两项测试的结果都十分有前景。经过10天的细胞培养,打印的细胞存活率高,增殖稳定,这表明打印的组织支架中的细胞具有良好的生物学功能。

生物打印实验设备
虽然这只是第一步,但这项研究已经证实了该概念在治疗胃壁损伤中的可行性。要使其完全实现,还需要做更多的工作,包括缩小生物打印平台的尺寸和开发生物墨水,未来的研究将集中在这些领域。
参考:
【1】https://www.genengnews.com/news/bioprinting-in-vivo-offers-potential-therapy-for-gastric-wounds/
【2】https://iopscience.iop.org/article/10.1088/1758-5090/aba4ff
